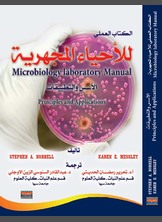
الأحياء المجهرية الأحياء المجهرية

ملخص كتاب كوكب الفيروسات
نظرة خاطفة على عالم الفيروسات المذهل
تاريخ النشر:
٢٠٢٣
الناشر:
عدد الصفحات:
١٢ صفحة
الصّيغة:
٥٠٠
شراء
نبذة عن الكتاب
في كل عام تنتشر الفيروسات الأنفية والانفلونزا في جميع أنحاء العالم، تاركة مئات الملايين يعانون من الزكام والسعال في أعقابها.
وعلى الرغم من أنّها تقتل عددًا من الأشخاص سنويا، فهناك فيروسات أسوأ وأكثر فتكا بكثير.
آخرُ تفشٍّ لفيروس الإيبولا قتل الآلاف، واليوم نسمع أخبارًا مروعة عن فيروس الكورونا المستجدّ.
وبسبب العولمة، يمكن أن تنتشر الفيروسات أبعد وأسرع من أي وقت مضى.
ولكن هل الفيروسات كلها سيئة؟ هل بإمكانهم إلحاق ضرر كبير بنا؟ وهل يمكننا الحدّ من أخطارها؟
وعلى الرغم من أنّها تقتل عددًا من الأشخاص سنويا، فهناك فيروسات أسوأ وأكثر فتكا بكثير.
آخرُ تفشٍّ لفيروس الإيبولا قتل الآلاف، واليوم نسمع أخبارًا مروعة عن فيروس الكورونا المستجدّ.
وبسبب العولمة، يمكن أن تنتشر الفيروسات أبعد وأسرع من أي وقت مضى.
ولكن هل الفيروسات كلها سيئة؟ هل بإمكانهم إلحاق ضرر كبير بنا؟ وهل يمكننا الحدّ من أخطارها؟
إضافة تعليق
لم يتم العثور على نتائج